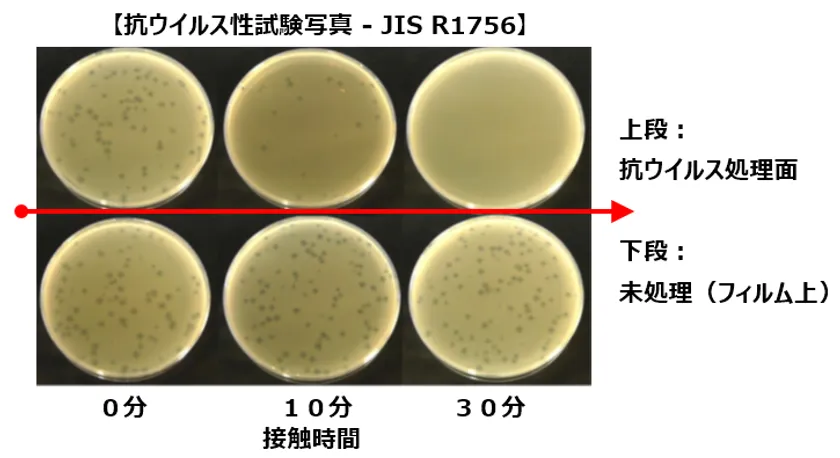

タッチパネル研究所「抗ウイルス・タッチパネル」を製品化 衛生管理が求められるATMや病院の 自動受付精算機向け等に本格提案を開始
株式会社タッチパネル研究所(本社:東京都八王子市、代表取締役:三谷 雄二)は、不特定多数の人々が利用し衛生管理が求められる病院の自動受付精算機、ATM、飲食店の注文端末や、院内感染対策が求められる医療機器向けに、今月よりその操作面に抗菌・抗ウイルス加工をした「抗ウイルス・タッチパネル」製品の提案を開始します。
■91%の一般消費者が『公共のタッチパネルに抗菌・抗ウイルス機能があった方が良い』と回答
現在、タッチパネルはスマートフォンをはじめとする個人端末から、ATMや自動券売機などの公共端末まで幅広く使われるようになりました。当社はそのうち不特定多数の人々が利用する公共のタッチパネルや、医療機器に搭載されているタッチパネルの衛生管理を考え、2016年からその操作面の抗菌化や抗ウイルス化に関する取り組みを行ってきました。
タッチパネル研究所が今月一般消費者843名を対象に行ったアンケート調査によると、全体の約91%が『公共のタッチパネルに抗菌・抗ウイルス機能があった方が良い』と回答しています。菌やウイルスの脅威が問題となる度に、人々の衛生意識は急速に高まっており、待ったなしの対策が求められています。

本製品の必要性アンケート
■菌は99.9%、ウイルスは99.99%の減少を確認 効果は持続
抗ウイルス材料には、東京大学先端科学技術研究センターでの研究成果に基づいて開発されたパナック株式会社の抗ウイルスフィルム - VIRtech(R)(ウィルテック)を使用しています。タッチパネル研究所では、このフィルムをタッチパネルの操作面に加工することで抗ウイルス機能を付与しています。

本製品の断面イメージ
VIRtech(R)は、主成分である酸化銅(I)が放出する電子がウイルスを攻撃し、細胞への感染力をなくすことでウイルスを不活性化させます。抗ウイルス性試験(JIS R1756)では99.99%のプラーク数の減少を、抗菌性試験(JIS R1702)でも99.9%のコロニー数の減少が確認されています。
主成分である酸化銅(I)は電子を放出した後、一時的に酸化銅(II)となり抗ウイルス効果が弱くなりますが、第二の成分である光再生半導体の作用により、室内光が当たれば再び酸化銅(I)に光還元されるため、抗ウイルス性能はずっと機能し続けます。

抗菌・抗ウイルス性試験結果 -1
抗菌・抗ウイルス性試験結果 -2
■タッチパネルの性能や外観を損なうことなく抗ウイルス加工
抗ウイルス加工することで、タッチパネル本来の性能を損なうことがあってはなりません。そこで、タッチパネル研究所では抗ウイルス加工後のタッチパネルの各種性能検証を行ってきました。タッチパネルの種類や仕様によっては、操作面に加工をすることで感度が悪くなったり動作しなくなったりするものがあります。また利用者が直接触れることになる操作面に深い傷が入ってしまった場合、その箇所の抗ウイルス効果が失われることになるため注意が必要です。
当社の抗ウイルス・タッチパネル製品は、抗ウイルス加工後においても通常動作に影響がないことを確認済。また、その操作面に対して10万回(10万文字)の筆記を行ってもキズが入らないことを社内試験で確認しています。

本製品操作面の筆記耐久試験
■タッチパネル本体への傷付き防止、視認性の向上、指紋を目立たなくする効果も
タッチパネルの操作面上に貼られる抗ウイルスフィルムは貼り換えが可能ですので、タッチパネル本体の保護フィルムとしても機能します。特に公共のタッチパネルは使用期間が長く、不特定多数の人々が利用することから、傷などの外的損傷が生じやすいですが、そのリスクも減らすことができます。また製品表面はノングレア(防眩)処理がされています※ので、画面への映り込みを抑え視認性を向上させると共に、付着した指紋を目立たなくさせる効果もあります。
※クリアタイプの相談にも応じます

本製品の表面処理
■ご使用中のタッチパネルの抗菌・抗ウイルス化に関する相談にも対応 - セットメーカーを対象に
「自社で製造・販売中の機器に搭載したタッチパネルを、後から抗菌・抗ウイルス化できないか?」といったセットメーカー(製造業者)からの相談にも対応します。当社製ではない他社製のタッチパネルでも、幾つかヒアリングさせていただくことで、タッチパネルの方式、機器の構造、市場への導入状況などに応じ、できる限りの提案を行います。
■製品概要
抗ウイルス・タッチパネルは、タッチパネル研究所・モニター事業部が販売中の下記製品の特別仕様品となります。
対応製品(一部非対応の製品型番があります。詳細はお問合せください)
●タッチパネル単品
●タッチパネル付LCDモジュール
●タッチモニター
●タッチテーブル、チャイルドテーブル
上記製品に関する詳細(タッチパネル研究所・モニター事業部ホームページ)
URL : https://touch-monitor.jp
対応画面サイズ: 3.5~32型
提案開始 : 2020年6月

抗ウイルス・タッチパネル対応製品
■会社概要
商号 : 株式会社タッチパネル研究所
代表者 : 代表取締役 三谷 雄二
所在地 : 東京都八王子市散田町5-27-19
設立 : 1998年5月
事業内容 : タッチパネル関連製品の製造・輸入販売
資本金 : 50百万円
取扱事業部URL: https://touch-monitor.jp
【本製品に関するお客様からのお問合せ先】
株式会社タッチパネル研究所・モニター事業部
お問合せフォーム: https://touch-monitor.jp/contact



















